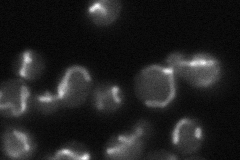
YML086C
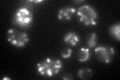
YML086C

View description
D-Arabinono-1,4-lactone oxidase, catalyzes the final step in biosynthesis of dehydro-D-arabinono-1,4-lactone, which is protective against oxidative stress
Localization:
Intensity:
Fold change:
Significance:
-
C’ GFP library in SD

mitochondria98.3 -
N' NOP1pr-GFP in SD

mitochondria169.074 -
N' TEF2pr-mCherry in SD

mitochondria214.767 -
N' NATIVEpr-GFP in SD
mitochondria41.1048 -
N' TEF2pr-VC and Cyto-VN in SD

#N/A0 -
C’ GFP library in SD+DTT

mitochondria101.491.03No -
C’ GFP library in SD+H2O2

mitochondria119.441.21No -
C’ GFP library in Starvation Media
mitochondria127.031.29No -
C’ GFP library on the background of Pup2-DaMP

mitochondria -
C’ GFP library on the background of CCT mutant

mitochondria102.5811.04348No
